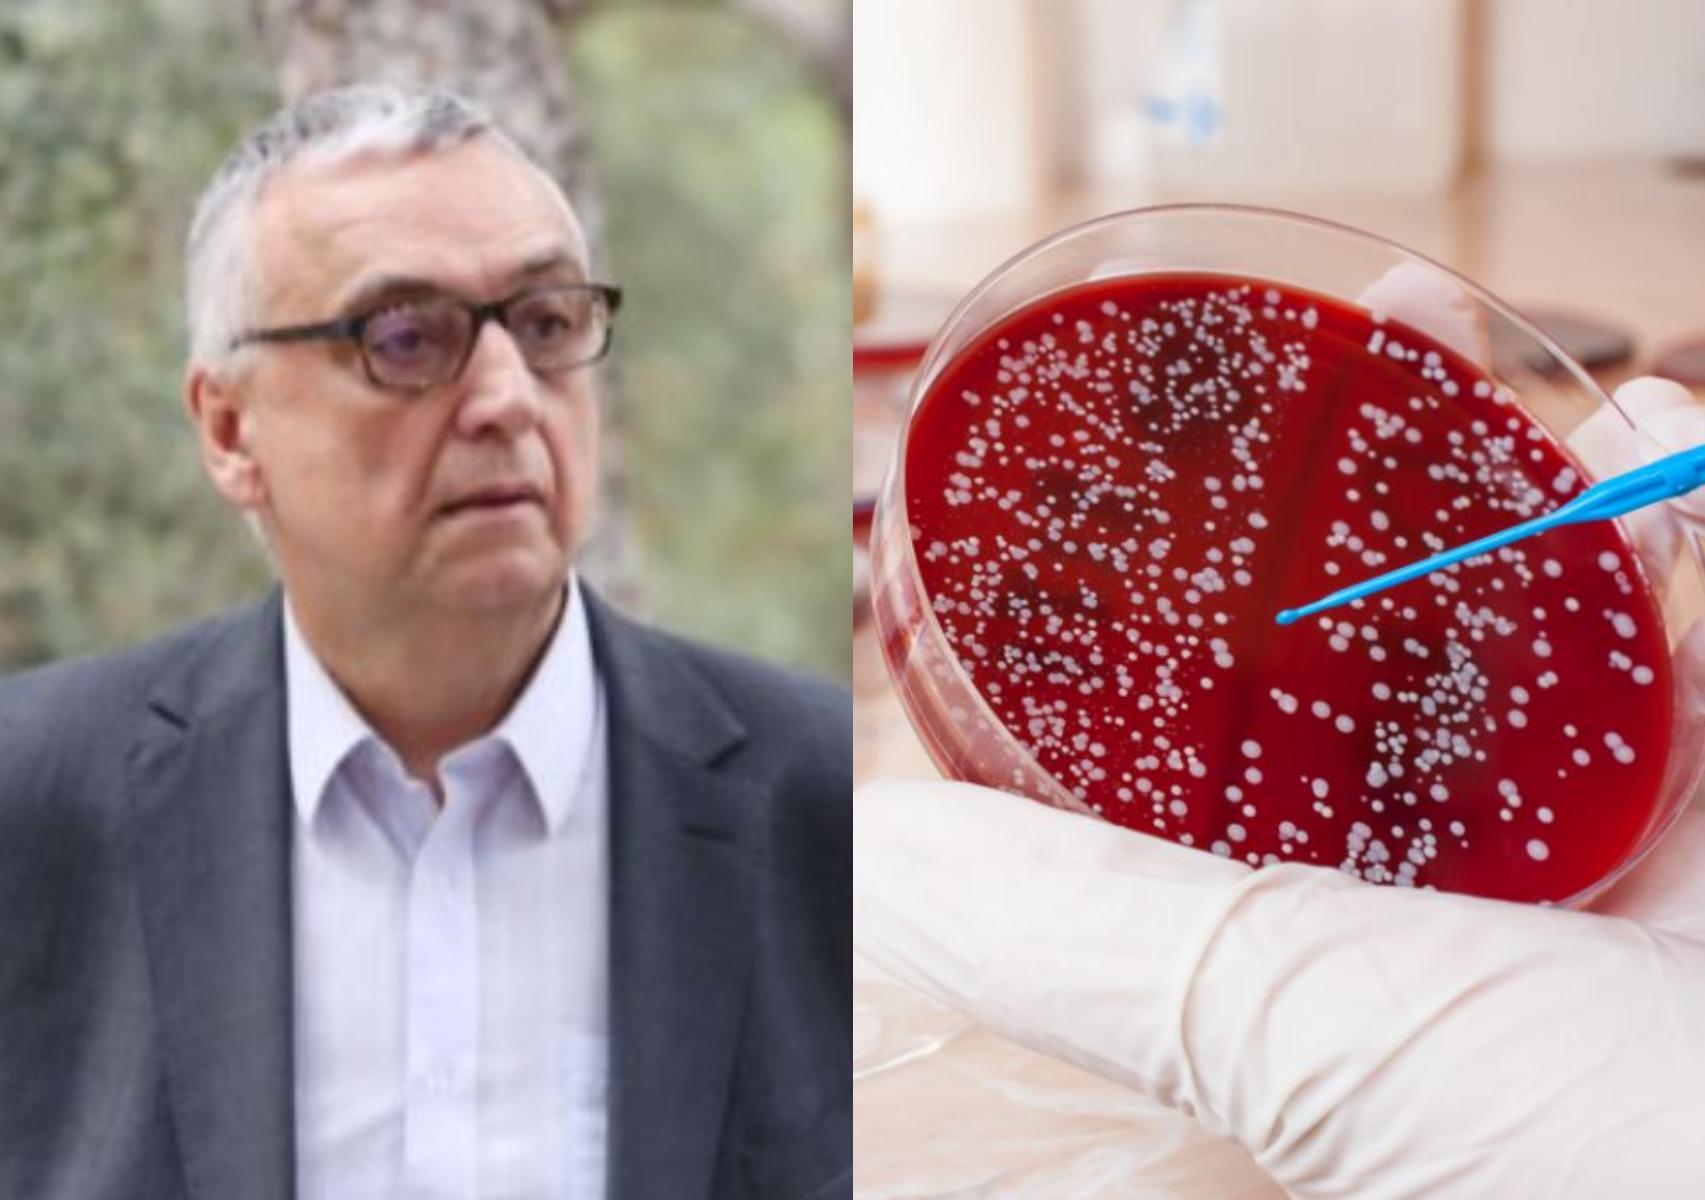
Τι είναι ο χρυσίζων σταφυλόκοκκος που προκάλεσε το ραγδαίο θάνατο του Δημήτρη Σούρα

Tην τελευταία του πνοή σε ηλικία 72 ετών άφησε ο γνωστός ψυχίατρος Δημήτρης Σούρας. Τι είναι ο χρυσίζων σταφυλόκοκκος που προκάλεσε το ραγδαίο θάνατο του.
Τι είναι ο χρυσίζων σταφυλόκοκκος που ευθύνεται για τον ξαφνικό θάνατο του γνωστού ψυχιάτρου Δημήτρη Σούρα.
Ο καθηγητής λοιμωξιολογίας Νικόλαος Σύψας εξηγεί την επικινδυνότητα του σταφυλόκοκκου και της ανθεκτικής του μορφής.
«Ο σταφυλόκοκκος είναι ένα μικρόβιο που βρίσκεται παντού στη φύση και στον άνθρωπο, στο δέρμα μας και τη μύτη μας. Μας αποικίζει», εξηγεί για το μικρόβιο ο κ. Νικόλαος Β. Σύψας, Καθηγητής ΕΚΠΑ, Πρόεδρος Ελληνικής Εταιρείας Λοιμώξεων, και διευκρινίζει τι ισχύει για το ανθεκτικό στέλεχος του βακτηρίου: «Το πρόβλημα είναι ότι, τα τελευταία 15-20 χρόνια έχει περάσει στην κοινότητα ένας σταφυλόκοκκος ανθεκτικός στα αντιβιοτικά, ο σταφυλόκοκκος χρυσίζων ανθεκτικός στη μεθικυλλίνη (Methicillin-resistant Staphylococcus aureus/MRSA), που τον βρίσκαμε στα νοσοκομεία».
Βουλωμένη μύτη: 5+1 τρόποι να την ξεβουλώσετε φυσικά

Photo via: www.tanea.gr
Ευάλωτες ομάδες
Σύμφωνα με τον κ. Σύψα, ο ανθεκτικός σταφυλόκοκκος εντοπίζεται γενικά σε συγκεκριμένες κατηγορίες ανθρώπων, όπως τα άτομα με διαβήτη, άτομα που ζουν μαζί όπως στις φυλακές, στους στρατώνες, άνθρωποι που ασχολούνται με ομαδικά σπορ και μολύνουν ο ένας τον άλλον. «Άλλες ευάλωτες ομάδες αποτελούν οι χρήστες ενδοφλεβίων ουσιών, άνθρωποι που ζουν σε κακές συνθήκες υγιεινής, όπως άστεγοι και μετανάστες» συμπληρώνει.
Βλάβες σε όλο τον οργανισμό
Ο σταφυλόκοκκος προκαλεί κυρίως δερματικές βλάβες, όπως δοθιήνες -βαθύτερες φλεγμονές του θυλάκου των τριχών-, μερικές φορές όμως περνά στο αίμα και προκαλεί βακτηριαιμία (ή σηψαιμία) από σταφυλόκοκκο, «μια κατάσταση απειλητική για τη ζωή που πρέπει να αναγνωρίσουμε πολύ γρήγορα, για να δώσουμε έγκαιρα ενδοφλέβια θεραπεία και να διασώσουμε τον ασθενή», εξηγεί.
Όπως αναφέρει, άτομα που κάνουν ενέσεις, π.χ. ενδοφλέβιες ή ενδομυϊκές, μπορούν να ενέσουν τον σταφυλόκοκκο στο σώμα και, επομένως, είτε βρεθεί στους μυς είτε στα οστά, να προκαλέσει αποστήματα, «μεγάλα αποστήματα τα οποία παροχετεύονται μόνο χειρουργικά. Τα αποστήματα αυτά αποτελούν αίτια βακτηριαιμίας».
Σύμφωνα με τον καθηγητή, μετά την είσοδό του στην κυκλοφορία, ο σταφυλόκοκκος μπορεί να φτάσει οπουδήποτε στο σώμα· «να πάει στους πνεύμονες και να προκαλέσει πνευμονία, στον εγκέφαλο εγκεφαλικό απόστημα, να πάει στην καρδιά και να κάνει ενδοκαρδίτιδα, στα οστά να κάνει οστεομυελίτιδα. Είναι ένα μικρόβιο που μπορεί να προσβάλλει οποιοδήποτε όργανο και σύστημα του οργανισμού μας».
Μικροβιολόγος εξηγεί : Γιατί πρέπει να αποφεύγουμε το στεγνωτήρα χεριών στις τουαλέτες

Συμπτώματα και πορεία λοίμωξης
Τα συμπτώματα εξαρτώνται από τον εντοπισμό της λοίμωξης, δηλαδή:
δερματικές βλάβες αν εντοπίζεται στο δέρμα τοπικό άλγος και πυρετό αν εντοπίζεται στους μυς και τα οστά συμπτώματα πνευμονίας (βήχα, υψηλό πυρετό, δύσπνοια και πόνο στο στήθος) αν εντοπίζεται στους πνεύμονες πολύ υψηλό πυρετό (πάνω από 40ºC) ή υποθερμία αν περάσει στο αίμα και, αν δεν χορηγηθεί άμεσα θεραπεία, οδηγεί σε πτώση της αρτηριακής πίεσης, ζάλη, σύγχυση κ.ο.κ..
«Γενικά, σε περίπτωση σηψαιμίας έχουμε πολύ υψηλό πυρετό και πολύ κακή γενική κατάσταση. Ο ασθενής είναι βαρέως πάσχων και φαίνεται» σημειώνει ο κ. Σύψας.
Σχετικά με την οργανική ανεπάρκεια, ο κ. Σύψας εξηγεί: «Στο τέλος, όταν ο ασθενής μπει στη σήψη, έχουμε συνήθως έναν καταρράκτη γεγονότων, μη αναστρέψιμων τις περισσότερες φορές, εκτός αν προλάβουμε πολύ νωρίς. Τα γεγονότα οδηγούν τον ασθενή στα στάδια με κυκλοφορική και αναπνευστική ανεπάρκεια, οπότε χρειάζεται μηχανική υποστήριξη (διασωλήνωση).
Ο κίνδυνος της μικροβιακής αντοχής
Τα επιδημιολογικά δεδομένα από το Ευρωπαϊκό Κέντρο Ελέγχου και Πρόληψης Νοσημάτων (ECDC) αποτυπώνουν μείωση στις λοιμώξεις από MRSA. «Αυτό ισχύει και στην Ελλάδα, ευτυχώς, παρότι έχουμε πολυανθεκτικά μικρόβια και, κυρίως, τα gram αρνητικά εντοβακτηριακά, στον σταφυλόκοκκο δεν αυξάνεται η συχνότητα, παραμένει σταθερή και ίσως έχουμε και ελαφρά πτωτική τάση. Επιδημιολογικά έχουμε μια σταθερότητα σε σχέση με τον MRSA» σχολιάζει.
24 έως 48 ώρες για το αντιβιόγραμμα
Σύμφωνα με τον κ. Σύψα, μεσολαβούν 24 έως 48 ώρες για να δείξει το αντιβιόγραμμα αν πρόκειται για ανθεκτικό στέλεχος. «Γι’ αυτό ο γιατρός πρέπει να έχει υποψία αν π.χ. ο ασθενής είναι διαβητικός, αν γνωρίζει ότι είναι αποικισμένος από ανθεκτικό σταφυλόκοκκο ή ανήκει στις ομάδες υψηλού κινδύνου ή είναι ανοσοτακατεσταλμένος, να δίνει την κατάλληλη αγωγή για MRSA εμπειρικά, μέχρι να βγει το αντιβιόγραμμα».
Καθώς τα ποσοστά αντοχής στην Ελλάδα είναι πολύ υψηλά, ο γιατρός και ο ασθενής πρέπει να αντιλαμβάνονται ότι κάτι δεν πάει καλά πολύ νωρίς, ώστε να ξεκινήσει την κατάλληλη θεραπεία –«γιατί έχουμε τα κατάλληλα αντιβιοτικά»– όσο το δυνατόν πιο έγκαιρα, πριν αρχίσει ο καταρράκτης των γεγονότων.
Σιδηροπενία : Ποια τα αίτια και πως να την αντιμετωπίσετε με διατροφή
Μέτρα προστασίας
Πολύ καλή ατομική υγιεινή (πλύσιμο χεριών, καθαρά ρούχα κ.λπ.) Αποφεύγουμε στενές επαφές (αγκαλιές, φιλιά κ.λπ.) με άτομα που έχουν δερματικές βλάβες ή οτιδήποτε άλλο Αυστηρή καθαριότητα όπου υπάρχει αυξημένος συγχρωτισμός (π.χ. αποδυτήρια) Πολύ καλή ρύθμιση του σακχάρου τα άτομα με διαβήτη Εάν ανήκουμε στις ομάδες υψηλού κινδύνου, σύμφωνα με το www.ygeiamou.gr άμεση ιατρική βοήθεια επί οποιωνδήποτε συμπτωμάτων.